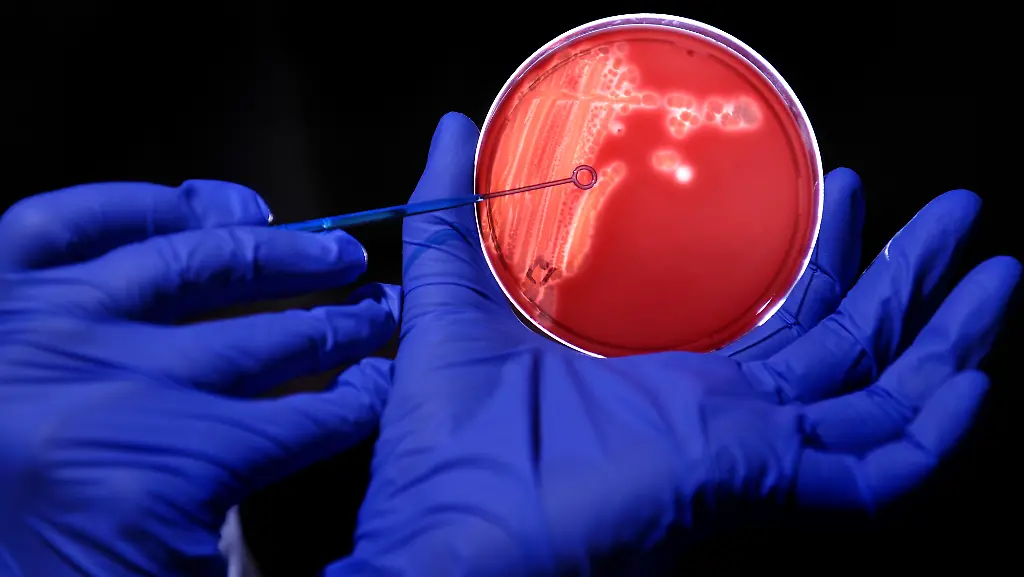
1306333868-jpg4858596238011669968

Tomaten, Gurken und Salate aus NorddeutschlandRKI warnt vor Gemüsesorten
Bundesweit, vor allem aber in Norddeutschland werden immer mehr Infektionen mit dem EHEC-Darmkeim bekannt. Bislang gibt es zwei bestätigte Todesfälle. Auch die Verdachtsfälle steigen weiter an - auf mehr als 600. Das Robert-Koch-Institut sucht fieberhaft nach dem Ursprung des Bakteriums. Es warnt mittlerweile vor verschiedenen Gemüsesorten aus Norddeutschland.
Die EHEC-Welle verläuft immer dramatischer. In Schleswig-Holstein starb eine weitere Frau nach einer Infektion mit dem aggressiven Darmkeim. Die 89-Jährige erlag in Oldenburg den Folgen des hämolytisch-urämischen Syndroms (HUS), einem besonders schweren Verlauf der Infektion. Es ist der zweite Todesfall, bei dem das gefährliche Bakterium nachweislich eine Rolle spielte. Bei mehreren weiteren Fällen besteht zudem der Verdacht, dass EHEC die Todesursache ist. Verbraucherschutzministerin Ilse Aigner bezeichnete die Ausbreitung als "besorgniserregend".
Das Robert Koch-Institut (RKI) in Berlin warnt inzwischen vor dem Verzehr von Salatgurken, Blattsalaten und rohen Tomaten insbesondere aus Norddeutschland. Eine epidemiologische Studie in Hamburg habe gezeigt, dass EHEC-Erkrankte diese Gemüse deutlich häufiger verzehrt hätten als gesunde Vergleichspersonen, teilten das RKI zusammen mit dem Institut für Risikobewertung in Berlin mit. Es steht den Angaben zufolge noch nicht fest, ob nur eines oder mehrere dieser drei Lebensmittel mit der Erkrankungswelle zusammenhängen. Da die Lieferketten noch erforscht werden ist unklar, ob das betroffene Gemüse aus Norddeutschland stammt oder nur vor allem dort verkauft wurde. Das Bundesverbraucherschutzministerium begrüßte die Warnung.
Der Mikrobiologe Roger Stephan warnte, das seit Tagen empfohlene Waschen von Gemüse biete keinen hundertprozentigen Schutz vor dem EHEC-Erreger. Die Bakterien könnten sich nicht nur auf der Oberfläche von Obst oder Gemüse befinden, sondern bereits von der Pflanze aufgenommen worden sein, sagte der Leiter des schweizerischen Instituts für Lebensmittelsicherheit an der Universität Zürich dem Bielefelder "Westfalen-Blatt". In diesem Fall müsse das Gemüse konsequent durcherhitzt werden.
"Bakterium ist hochinfektiös"
Derzeit erlebe Deutschland den stärksten je registrierten EHEC-Ausbruch, sagte RKI-Chef Reinhard Burger. Es gebe so viele Erkrankte pro Woche wie sonst in einem Jahr. Das Bakterium sei hochinfektiös, schon 10 bis 100 Keime genügen für eine Ansteckung. Die Zahl der Patienten, die sich mit EHEC infiziert haben, nimmt rasch zu. Deutschlandweit sind mehr als 600 Fälle registriert, von denen aber noch nicht alle bestätigt sind. Am Dienstag waren es noch etwa 460. Beim RKI wurden bis Dienstagabend rund 140 schwere Krankheitsverläufe mit blutigem Durchfall und Nierenversagen gemeldet. Noch am Dienstagmittag hatte das RKI 80 solcher Fälle registriert.
In der neuen Studie hatten das RKI und Hamburger Behörden die Speisen von 25 Erkrankten und 96 Gesunden vergleichbaren Alters und Geschlechts in der Hansestadt analysiert. Es habe signifikante Unterschiede gegeben: Zwei Drittel aller Patienten mit der EHEC-Folgeerkrankung HUS hätten Salat, Tomaten und Gurken verzehrt, aber nur ein Drittel der Gesunden. Besonders deutlich sei das statistische Signal bei Tomaten gewesen. Ursache für die Verschmutzung des Gemüses könnten Fäkalien von Mensch oder Tier sein, sagte Burger. Üblicherweise reiche eine Erhitzung der Speisen für zwei Minuten auf 70 Grad Celsius, um den Keim abzutöten. In Fleisch, Milch und Käse seien bislang keine Erreger gefunden worden.
Schwerpunkt Norddeutschland
Meldungen über bestätigte Infektionen oder Verdachtsfälle kommen mittlerweile aus 15 Bundesländern. Der Schwerpunkt der Infektionen liegt in Norddeutschland. In Niedersachsen litten mehr als 130 Patienten an Durchfallerkrankungen, die von dem EHEC-Darmkeim ausgelöst worden sein könnten. In Schleswig-Holstein und Hamburg meldeten die Behörden inzwischen mehr als 400 Fälle, bei denen Menschen erkrankt sind oder sich vermutlich angesteckt haben.
Das Universitätsklinikum Hamburg-Eppendorf (UKE) befürchtet, dass dort infizierte Patienten sterben werden. "Wir müssen damit rechnen, Patienten zu verlieren", sagte der Nierenspezialist Prof. Rolf Stahl. Es gebe einige schwer Erkrankte am UKE. Nach Angaben des Krankenhauses werden derzeit 33 Erwachsene und 14 Kinder behandelt. Der ärztliche Direktor Prof. Jörg Debatin sagte, es sei die größte Herausforderung für das Krankenhaus seit mehreren Jahren.
Das RKI teilte mit, die Zahl der schweren Verläufe in einem kurzen Zeitraum sei sehr ungewöhnlich. Auch die betroffenen Altersgruppen seien untypisch. Aktuell seien vor allem Erwachsene, überwiegend Frauen, betroffen. In den vergangenen Jahren gab es nur 60 bis 70 HUS-Fälle pro Jahr, und zumeist waren Kinder erkrankt.
Großes RKI-Team eingebunden
RKI-Chef Burger sagte, er erwarte ein Abflauen bei den grassierenden EHEC-Infektionen, wenn das die Bakterien enthaltende Lebensmittel gefunden wird oder es sich um ein Lebensmittel von kurzer Haltbarkeit handelt. Obwohl ein großes RKI-Team unter Hochdruck nach dem Infektionsherd sucht, sei bisher aber noch kein einzelnes Lebensmittel als Quelle identifiziert worden. Da Frauen am meisten betroffen seien, liege die Interpretation nahe, dass sie sich bei der Verarbeitung von Lebensmitteln infiziert hätten.
Gülle als Ursache sei "natürlich theoretisch eine Erklärung", aber dafür gebe es keine Daten, sagte Burger. Gemüsebauern wehrten sich gegen einen solchen Verdacht. "Das Gemüse würde ein Ausbringen von Gülle doch gar nicht aushalten, das macht keiner", sagte der Geschäftsführer des Erzeugerrings Knoblauchsland, Anton Offenberger.
Eine Sprecherin des RKI sagte, es könne noch Tage oder Wochen dauern, bis der Ursprung gefunden werde. "In der Vergangenheit hatten wir es mit viel kleineren Ausbrüchen zu tun", sagte die Sprecherin. "Manchmal konnte das sehr schnell eingegrenzt werden. Aber es gab auch Ausbrüche, in denen man einfach nichts zum Ursprung gefunden hat."
Salatbars im Verdacht
Über die Herkunft des Erregers wollte sie nicht spekulieren. "Es bleibt dabei, dass es bislang keine Hinweise darauf gibt, dass die Erreger aus Fleisch oder Rohmilch stammen. Es könnte Gemüse sein, aber auch ein anderes Lebensmittel." Die ärztliche Leiterin des Großlabors Medilys der Asklepios-Kliniken in Hamburg, Susanne Huggett, äußerte bei n-tv den Verdacht, dass im Moment Salatbars, "also vorbereitete Salatteile eine Rolle spielen".
Verbraucherministerin Aigner beschwichtigte Ängste vor einer Ansteckung. "Auf Gemüse muss niemand verzichten", sagte sie der "Passauer Neuen Presse". "Grundsätzlich sollten vor dem Verzehr stets die allgemeinen Hygiene-Empfehlungen beachtet werden."
Bundesgesundheitsminister Daniel Bahr hält die bestehenden Mechanismen im Kampf gegen die EHEC-Verbreitung für ausreichend. "Ein Krisenstab würde dann eingerichtet, wenn es übergeordneten Handlungsbedarf gäbe", sagte ein Sprecher von Bahr. Im Fall der EHEC-Welle würden die Bürger über das RKI, die Bundeszentrale für gesundheitliche Aufklärung, das Verbraucherministerium sowie die Hotline des Gesundheitsministeriums (01805 - 996601) informiert.